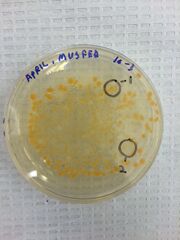
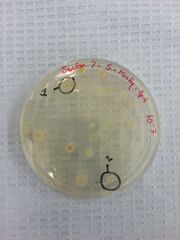

Uploads by Musfeq Us Salehin Patoary
From OpenWetWare
Jump to navigationJump to search
This special page shows all uploaded files.
| Date | Name | Thumbnail | Size | Description |
|---|---|---|---|---|
| 20:49, 19 March 2015 | Rony.jpg (file) |  |
1.56 MB | |
| 21:07, 12 February 2015 | IMG 4240 feb12th.JPG (file) |  |
74 KB | |
| 21:06, 12 February 2015 | IMG 4241 feb12th.JPG (file) |  |
74 KB | |
| 21:06, 12 February 2015 | IMG 4243 feb12th.JPG (file) |  |
69 KB | |
| 21:04, 12 February 2015 | IMG 4244 feb12th.JPG (file) |  |
64 KB | |
| 21:04, 12 February 2015 | IMG 4245 feb12h.JPG (file) |  |
90 KB | |
| 21:00, 12 February 2015 | Feb12th lab data.jpg (file) |  |
313 KB | |
| 20:44, 12 February 2015 | Data and Observations february 12th.docx (file) | 12 KB | ||
| 06:49, 5 February 2015 | Musfeq1.JPG (file) |  |
94 KB | |
| 06:42, 5 February 2015 | IMG 4191lab 4th feb.JPG (file) |  |
130 KB | |
| 06:42, 5 February 2015 | IMG 4189 lab 4th feb.JPG (file) |  |
144 KB | |
| 06:41, 5 February 2015 | IMG 2140 lab 4th feb.JPG (file) | |
96 KB | |
| 06:40, 5 February 2015 | IMG 2139 lab 4th feb.JPG (file) | |
94 KB | |
| 06:05, 5 February 2015 | February 4th lab.docx (file) | 15 KB | ||
| 06:49, 29 January 2015 | Bio 210 lab2.jpg (file) |  |
178 KB | |
| 02:29, 27 January 2015 | Transect 5.jpg (file) |  |
501 KB |